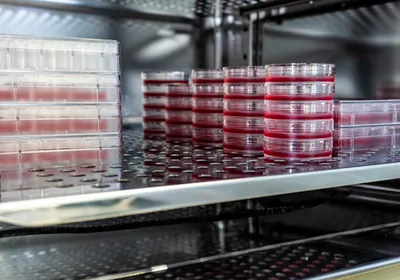

respiration
Trending

How a Forensic Biologist Exposed a DNA Lab Scandal That Shook Australia
After reviewing DNA evidence from a cold case murder, Kirsty Wright uncovered systemic flaws and deception in a forensics laboratory in Queensland, Australia.

Universe 25 Experiment
A series of rodent experiments showed that even with abundant food and water, personal space is essential to prevent societal collapse, but Universe 25's relevance to humans remains disputed.

One Gene Influences 75 Percent of Alzheimer’s Disease Cases
The apolipoprotein E (APOE) ε3 and ε4 gene variants may cause nearly half of all dementia cases.

Postdoc Portrait: Rohita Roy
This postdoc designs synthetic gene circuits applications in diagnostics, environmental sensing, and therapeutics.
Multimedia

From Data to Discovery: Omics in Therapeutic Innovation
In this symposium, researchers will examine the role of omics and multiomics approaches in accelerating drug discovery research, including the integration of spatial techniques.

Exploring Organoids for Disease Modeling Research
In this symposium, researchers will uncover the promising ways in which they use tissue-specific organoids to model diseases, understand how disorders develop, and uncover new treatment options.